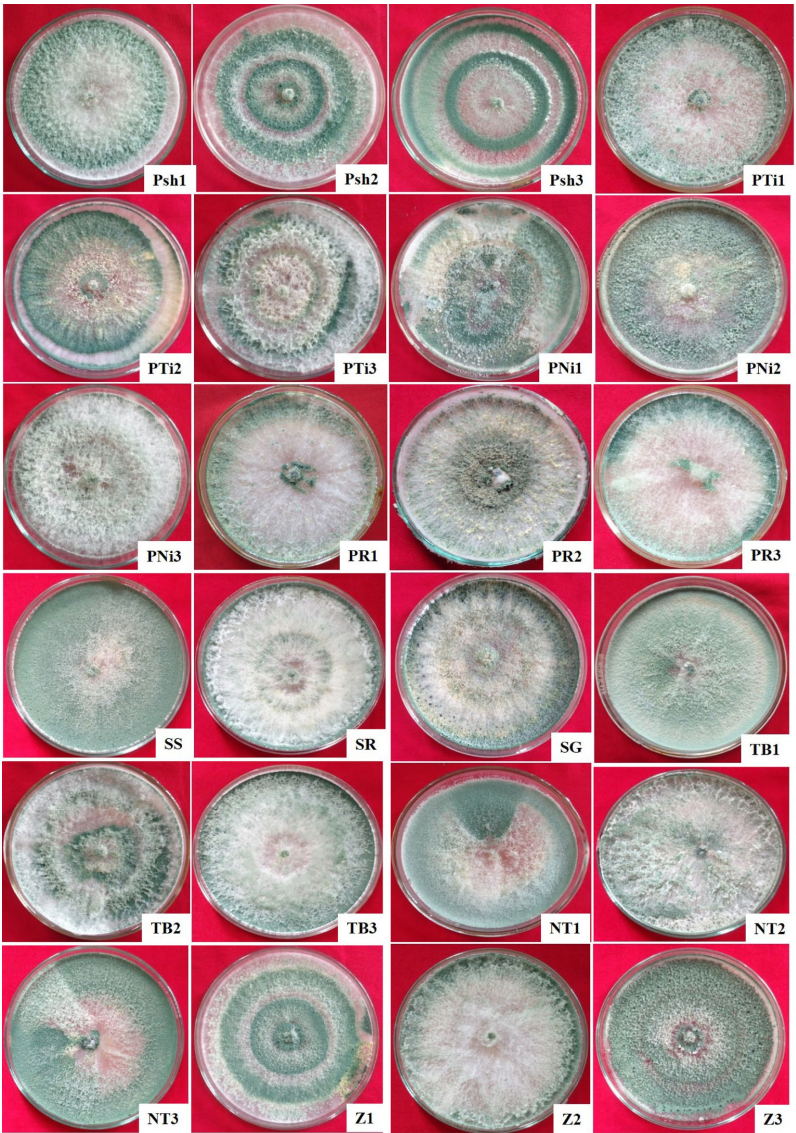

-
生物通官微
陪你抓住生命科技
跳动的脉搏
印度西北喜马拉雅苹果根际木霉菌的形态-培养与分子特征及其生物防治潜力
【字体: 大 中 小 】 时间:2025年07月21日 来源:Scientific Reports 3.8
编辑推荐:
本研究针对苹果种植中化学农药使用带来的环境与健康问题,通过整合形态学、培养特征与多基因(ITS、TEF 1-α和RPB2)分子标记技术,首次系统鉴定了印度查谟和克什米尔地区苹果根际的24株木霉菌,发现6个物种(包括T. koningiopsis等5个新记录种),为开发本地化生物防治菌剂提供了重要资源。
在印度查谟和克什米尔地区,苹果作为最重要的经济作物,面临着由Dematophora necatrix和Phytopthora cactorum等病原体引起的白根腐病和颈腐病的严重威胁。传统化学农药的过度使用不仅导致土壤和水源污染,还可能对人类健康产生负面影响。这一严峻形势促使科学家们将目光转向环境友好的生物防治方案,其中木霉菌(Trichoderma)因其广谱抗病原菌能力和植物促生作用,成为最具潜力的生物防治剂候选。然而,准确鉴定木霉菌物种是开发生物防治产品的关键前提,但仅依赖传统形态学方法存在30-50%的误判率,亟需建立更可靠的鉴定体系。
针对这一挑战,印度Sher-e-Kashmir农业科学与技术大学(SKUAST-K)植物病理学与分子病理学实验室的研究团队开展了一项创新性研究。研究人员从查谟和克什米尔两个地区的苹果根际土壤中分离获得24株木霉菌,通过整合形态-培养特征观察与多基因(ITS、TEF 1-α和RPB2)分子标记技术,系统鉴定了这些菌株的分类地位,相关成果发表在《Scientific Reports》上。
研究团队主要采用了三种关键技术:1)形态学鉴定(菌落特征、分生孢子形态等);2)分子标记技术(ITS区域、TEF 1-α和RPB2基因的PCR扩增与测序);3)多基因联合系统发育分析。样本来源于印度西北喜马拉雅地区两个主要苹果种植区的根际土壤。
Morpho-cultural characterization of the trichoderma isolates
通过菌落形态观察,24个分离株被分为四组:棉絮状(33.33%)、蓬松状(41.67%)和天鹅绒状(25%)。分生孢子颜色呈现亮绿、黄绿、淡绿和橄榄绿四种类型,形状包括亚球形、球形和亚圆柱形等。基于这些特征,初步鉴定为T. harzianum复合群(4株)、T. koningiopsis(4株)、T. viride(6株)和T. hamatum(10株)。
Molecular characterization of Trichoderma species
分子分析显示,基于ITS区域的系统发育分析将菌株分为5个分支,而TEF 1-α和RPB2基因分析则识别出6个明确物种。值得注意的是,单独使用ITS区域无法区分亲缘关系相近的物种,如T. viride和T. harzianum复合群。最终整合分析确定了6个物种:T. koningiopsis(5株)、T. viride(5株)、T. asperellum(3株)、T. asperelloides(4株)、T. hamatum(3株)和T. harzianum复合群(4株)。

这项研究首次报道了T. koningiopsis、T. viride、T. asperellum、T. asperelloides和T. hamatum在苹果根际的存在,填补了印度特别是查谟和克什米尔地区木霉菌多样性研究的空白。研究建立的形态-分子整合鉴定体系为木霉菌资源的准确鉴定提供了可靠方案,筛选出的本地菌株为开发针对苹果土传病害的生物防治产品奠定了重要基础。这些发现不仅丰富了木霉菌种质资源库,也为可持续农业实践提供了新的解决方案,有望减少化学农药依赖,保护喜马拉雅地区脆弱的山地生态系统。
生物通微信公众号
知名企业招聘